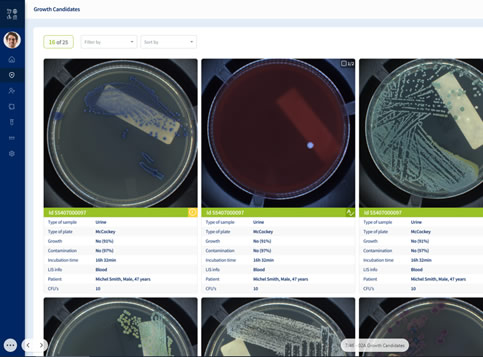

AIPLAK incuba y digitaliza las muestras, simplificando la interpretación para los técnicos. Su diseño compacto y modular, con cámaras independientes y captura de imágenes dual, introduce herramientas eficientes para la gestión del flujo de trabajo basadas en la criticidad de las muestras.

Incubadora automática
con sistema de interpretación
AUTOPLAK realiza la incubación de las muestras biológicas bajo condiciones controladas para garantizar un crecicmiento óptimo. Posteriormente, digitaliza las muestras con gran precisión, lo que agiliza la interpretación y acelera los procesos de trabajo para los técnicos de laboratorio.
Además, puede integrarse con módulos exclusivos de inteligencia artificial que permiten un monitoreo continuo y en tiempo real de las muestras críticas.

AIPLAK ofrece una incubación modular, eficiente y precisa mediante un sistema de incubación dual con 2 cámaras. Estas cámaras son totalmente personalizables para adaptarse a los protocolos del laboratorio, mejorando la flexibilidad y precisión en el proceso de incubación, y asegurando un rendimiento óptimo en diversas aplicaciones.
Aplicación de escritorio especializada que permite una gestión de datos eficiente, reduce errores y digitaliza por completo el flujo de trabajo. Diseñada para adaptarse a las distintas necesidades del laboratorio, gestiona e identifica las muestras de forma digital, mejorando la eficiencia operativa al eliminar el contacto físico y optimizando los procesos para alcanzar una mayor precisión y productividad.

Después del análisis realizado por el técnico a través de la interfaz gráfica, las muestras se descartan en la papelera o se ordenan y disponen en los carruseles de salida. El orden es configurable por el laboratorio a través de la configuración del sistema. Este orden facilita la transferencia de las muestras a los procesos posteriores de interpretación.

Incubación de alta calidad y personalizable
El mejor aprovechamiento del espacio en el mercado, solo requiere acceso frontal
Digitalización de la incubación, lectura e interpretación de muestras
Sistema conectado o independiente, con 2 cámaras de incubación independientes
Sistema de imagen dual
Mínimo impacto en la operativa diaria

La interfaz gráfica está diseñada para que los usuarios puedan navegar de manera sencilla e intuitiva por todas las funcionalidades disponibles. Soporta múltiples usuarios y perfiles, proporcionando acceso y funcionalidades personalizadas según cada rol. Su diseño y estructura ofrecen una experiencia clara y amigable que simplifica las operaciones diarias y mejora la eficiencia del flujo de trabajo.

Los usuarios pueden acercar y alejar la vista de las muestras de manera sencilla mientras las observan bajo distintas condiciones de iluminación. Esta funcionalidad proporciona una visualización mejorada y mayor flexibilidad, permitiendo inspeccionar las muestras en detalle desde múltiples perspectivas. Al ajustar la magnificación y la iluminación, los usuarios obtienen una visión más clara y completa, mejorando la precisión del análisis y la eficiencia del flujo de trabajo.

Los usuarios pueden etiquetar y definir fácilmente los procesos de trabajo, lo que permite una identificación y organización clara de cada etapa. Pueden asignar etiquetas, categorizar procedimientos y configurar parámetros según protocolos específicos. Esta funcionalidad garantiza un seguimiento preciso, simplifica la gestión del flujo de trabajo y aumenta la eficiencia general en el procesamiento de muestras.

El sistema de incubación inteligente es el único en el mercado equipado con 2 sistemas de imágenes complementarios. Un primer sistema de monitoreo continuo que permite el seguimiento ininterrumpido del crecimiento de la muestra, siendo capaz de generar alarmas tan pronto como se detecte el crecimiento en la muestra. El segundo sistema captura la imagen superior, digitalizando la muestra y ejecutando algoritmos de inteligencia artificial para determinar las características de ese crecimiento. Esta plataforma avanzada que combina protocolos de gestión basados en el tiempo y en el crecimiento, proporciona al laboratorio una herramienta única para abordar situaciones de emergencia, optimizar eficientemente los procesos de flujo de trabajo y contribuir así a una operación más efectiva y resultados acelerados en el laboratorio.
Acelera la detección con el
sistema de monitoreo continuo

No se trata solo de automatización,
se trata de agregar valor a través de la automatización
Experimenta el futuro de la microbiología clínica con el AIPLAK. ¡Acelera la detección con excelencia en lectura continua!
Contacto